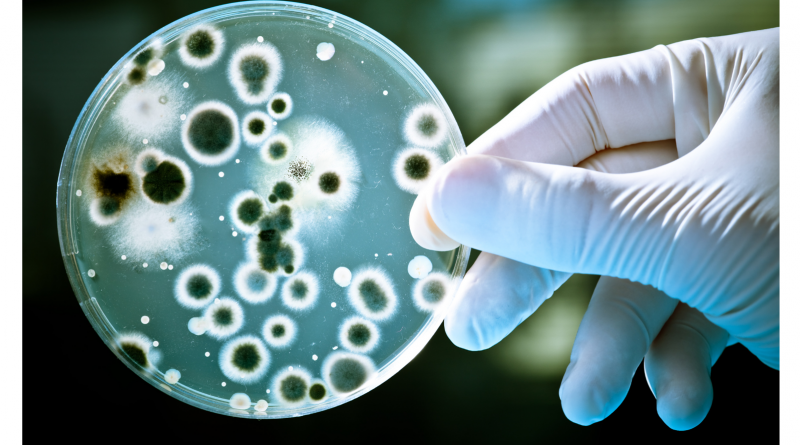

A través del diseño de sensores químicos a escala nanométrica se podrán determinar contaminantes emergentes en muestras de agua y micotoxinas en alimentos derivados de cereales. Especialistas de las universidades nacionales de San Luis (UNSL), San Martín (UNSAM), Cuyo (UNCuyo) y Córdoba (UNC), se nuclean en una red federal de alto impacto para estos estudios.
Con un subsidio de un (1) millón de dólares, otorgado por el Ministerio de Ciencia, Tecnología e Innovación de la Nación, los equipos científicos diseñarán sensores químicos nanoestructurados para la determinación de contaminantes en agua y alimentos. Por la UNSL interviene el Laboratorio de Bioanalítica del Instituto de Química San Luis (INQUISAL). La directora del grupo UNSL/Conicet es la Dra. Sirley Vanesa Pereira.
Los estudios se abocarán al diseño de sensores que serán aplicados a la determinación de contaminantes emergentes, tales como: fármacos, hormonas y sustancias químicas presentes en elementos de cuidado personal, en muestras de agua. Por otro lado, se desarrollarán sensores que serán aplicados a la determinación de micotoxinas (compuestos tóxicos producidos por hongos) en cereales y alimentos derivados de cereales.
La científica sostuvo que las plantas de tratamiento de aguas residuales no son eficientes para eliminar estos tipos de compuestos que pueden llegar tanto al hombre como a los animales y causar efectos adversos en su salud. Por esto es importante contar con herramientas de monitoreo para mantener el control de la calidad del agua.
Profesionales del Laboratorio de Bioanalítica
Respecto a la presencia de micotoxinas en cereales, la doctora Pereira expresó que conllevaría a pérdidas de productos alimenticios, así como pérdidas económicas por los efectos en la salud humana, en la productividad animal y en el comercio. «En este sentido es importante contar con dispositivos portátiles y miniaturizados, como los que planteamos desarrollar, para el control de la presencia de estas micotoxinas en estas materias primas y alimentos», resaltó.
Cada uno de los grupos que integra la red posee experticia en temáticas específicas. Junto al Laboratorio del Bioanalítica de San Luis, trabajarán profesionales del Laboratorio de Nanoarquitectura de la Universidad Nacional de San Martín (UNSAM), del Laboratorio de Química Analítica Verde del Instituto de Biología Agrícola de Mendoza (IBAM) de la Universidad Nacional de Cuyo (UNCuyo), y del Laboratorio de Caracterización Espectroscópica y Electroquímica de Materiales del Instituto de Investigaciones en Físico-Química (INFIQC) de la Universidad Nacional de Córdoba (UNC).
En la UNSAM se encargarán de sintetizar los nanomateriales. En San Luis se incorporarán esos nanomateriales a plataformas desarrolladas y se funcionalizarán con elementos de reconocimiento biológico para la detección de micotoxinas en agroalimentos. En la UNCuyo se abocarán al desarrollo de sensores ópticos para la determinación de contaminantes emergentes, y la UNC se encargará de la caracterización de los dispositivos diseñados.
«El trabajo de esta red nos permitirá acceder al financiamiento con el cual se podrá adquirir equipamientos e insumos necesarios, pero además el trabajo conjunto y multidisciplinario fortalecerá las capacidades existentes en el grupo, las potenciará y nos dará la posibilidad de incorporar nuevos conocimientos inherentes al resto de los grupos que conforman la red que son de reconocida trayectoria», resaltó Pereira.
Dato
El equipo local que dirige la Dra. Sirley Vanesa Pereira está integrado por el Dr. Andrés Takara, la Dra. Sofía Piguillem, la Lic. Andrea Ferroni y el Lic. Francisco Jofré.
Las actividades conjuntas se llevarán a cabo mediante estancias en los diferentes establecimientos conforme se avance con el desarrollo de los sensores. Habrá simposios, seminarios, estancias cortas, estancias en el exterior y reuniones de seguimiento para verificar el cumplimiento de los objetivos de la red.
El proyecto Diseño Integral de Sensores Químicos Nanoestructurados (NANOQUIMISENS) es uno de los 23 proyectos seleccionados por los proyectos de Redes Federales de Alto Impacto del Ministerio
Fuente: Prensa UNSL.
Seguir leyendo:
La CNEA busca impulsar sus proyectos en nanotecnología, con apoyo de la FAN
Lanzan la 4° Convocatoria del Régimen de Promoción de la Bio y Nanotecnología Modernas